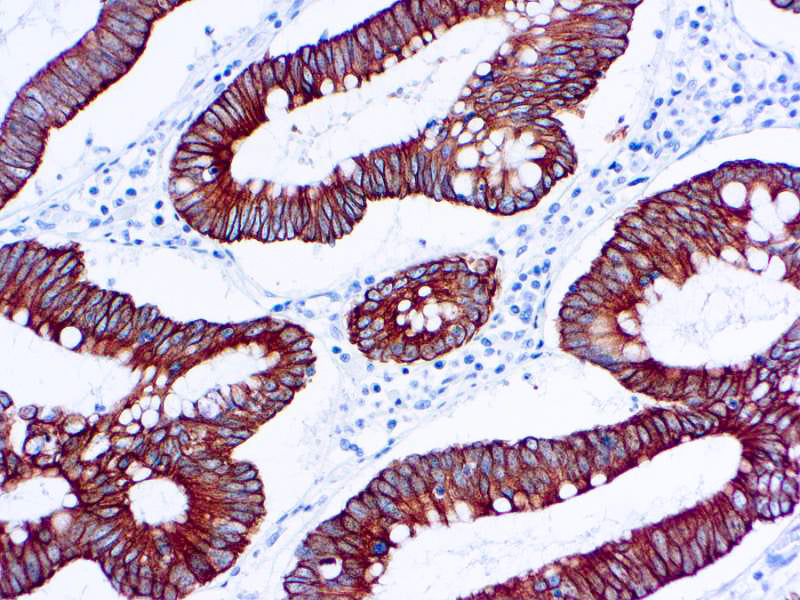

1
/
of
1
Dbiosys
SKU:Mob187
Cytokeratin 18
Cytokeratin 18
Regular price
$499.00 USD
Regular price
Sale price
$499.00 USD
Unit price
/
per
Shipping calculated at checkout.
Couldn't load pickup availability
This antibody is specific to human cytokeratin 18 of 45 kDa. Cytokeratin 18 belongs to a family of acidic type A keratins and exists along with cytokeratin 8 in most simple ductal and glandular epithelia. This antibody does not react with squamous epithelium. It reacts with benign and malignant epithelial lesions as well as a majority of adenocarcinomas and basal cell carcinomas.
Share